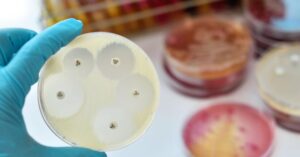

Resistencia antimicrobiana: actuar hoy para asegurar nuestro futuro
18 de noviembre 2025

Se trata de una pandemia que amenaza con revertir décadas de avances en medicina humana y animal. La resistencia a los antimicrobianos está provocando que enfermedades tradicionalmente tratadas con antibióticos sean cada vez más difíciles de controlar. Chile se encuentra entre los países en el mundo en los cuales la resistencia antimicrobiana seguirá aumentando.
En 2050, la primera causa de muerte en el mundo será la resistencia a los antimicrobianos. Según un estudio publicado en The Lancet, 8,22 millones de decesos en todo el mundo estarían asociados a la resistencia a los antimicrobianos, entre estos medicamentos se encuentran los antibióticos, cuyo uso excesivo ha permitido que las bacterias -microorganismos que han sobrevivido en el planeta por millones de años- aceleren la evolución de sus mecanismos, ante lo cual muchos medicamentos pierden eficacia.
En el marco de la Semana de Concientización de la Resistencia a los Antimicrobianos, campaña impulsada por la Organización Mundial de la Salud (OMS) y cuyo lema este año es “Actuemos ya: protejamos nuestro presente, aseguremos nuestro futuro”, académicos de la UC llaman a la población a cambiar hábitos como la automedicación o prescripción innecesaria.
El escenario futuro en nuestro país es preocupante. Así lo señala la Dra. Patricia García, Jefe del Laboratorio de Microbiología y Parasitología de la UC y profesora titular de esta casa de estudios: “Chile está entre los países donde el uso de antimicrobianos seguirá creciendo. Si no reforzamos la vigilancia y el uso responsable, la resistencia bacteriana será una de las principales causas de muerte al 2050”, advierte.

Superbacterias
El uso inadecuado de antibióticos -sin una correcta prescripción médica, en exceso o por no completar el tratamiento- facilita el desarrollo de “superbacterias”. Las infecciones permanecen en el organismo, y no solo afectan al portador, sino que pueden transmitirse por contacto directo, alimentos, agua o superficies.
En esta línea, el Dr. Patricio Ross, académico UC que forma parte del Programa de Optimización de Uso de Antimicrobianos (PROA) en la Red UC Christus, señala que es un problema sistémico con diversas aristas accionables: “Estamos hablando de un desafío ecológico, no es solo personal. Puede generarle daño a la gente que yo quiero, a la gente que vive conmigo”.
Además, existe una fuerte relación entre alta resistencia microbiana e inequidad. Así lo explica la Dra. Andrea Moreno, académica de la UC y Directora de la Escuela de Medicina Veterinaria de esta universidad.
“Hoy día entendemos que la resistencia bacteriana se asocia muchísimo a la contaminación de ambientes y, cuando hay contaminación, por supuesto que los más afectados son las familias y las comunidades con menos recursos. En Chile todavía hay localidades donde no hay acceso a agua potable, ni una buena eliminación de desechos humanos y de animales”, afirma.

La Dra. Moreno recalca que este desafío requiere afrontarse desde la mirada de Una Salud: “A través de esta aproximación colaborativa e interdisciplinaria podremos abordar un fenómeno transversal que afecta a personas, animales domésticos, animales de producción y fauna silvestre”.
Responsabilidad personal y conciencia colectiva
Los tres académicos de la UC reiteran la necesidad de educar a la comunidad en la responsabilidad personal y en la adopción de una mirada crítica sobre la medicación que reciben y sus efectos. El Dr. Ross comenta que “muchas veces, las personas no entienden para qué se usan los antibióticos, llegando a confundirlos con antiinflamatorios”.

Por otra parte, coinciden en que otra situación difícil de abordar, y que se observa habitualmente en consultas de medicina humana y animal, es la presión de pacientes y tutores de mascotas para conseguir una receta de antibióticos. Asimismo, mencionan la alarmante venta sin receta en farmacias y en ferias, donde circulan blíster sin caja.
Actuar ya es el urgente llamado que este año hace la campaña de la OMS y que deja claro que el tiempo se agota, cada segundo cuenta si consideramos que una bacteria puede llegar a duplicarse en solo veinte minutos. Así como hoy somos conscientes de la urgencia de cuidar el medioambiente pensando en las futuras generaciones, debemos comprender que con el aumento de la resistencia a los antimicrobianos el mundo se está jugando la vida. Tal como lo indica la Dra. Patricia García: “Podemos salvar al planeta, pero si no actuamos ahora, los seres humanos no estaremos para cohabitarlo».

Cifras:
• 4,71 millones de muertes asociadas a la RAM en 2021.
• 8,22 millones de muertes asociadas proyectadas para 2050.
• +80% de aumento de muertes en adultos mayores de 70 años (1990–2021).
Fuente: Carga mundial de la resistencia bacteriana a los antimicrobianos 1990-2021: un análisis sistemático con proyecciones hasta 2050 (The Lancet)
Vías de transmisión de bacterias resistentes:
• Contacto directo: al tocar o convivir con alguien portador de bacterias resistentes
• Alimentos: consumo de productos de origen animal y vegetal contaminados con bacterias resistentes.
• Agua: las bacterias resistentes pueden llegar a ríos y sistemas de agua a través de desechos humanos y animales, para luego volver a las personas por el consumo o el uso del agua contaminada.
• Ambiente: las bacterias resistentes también pueden estar presentes en el suelo, en superficies o dispersarse por el aire.
Acciones clave para reducir la RAM:
• Usar antibióticos solo con indicación profesional una vez realizado un diagnóstico preciso.
• Completar los tratamientos.
• Evitar la automedicación.
• Cuidar la higiene y el lavado de manos.
• Implementar buenas prácticas y un uso responsable en producción animal.